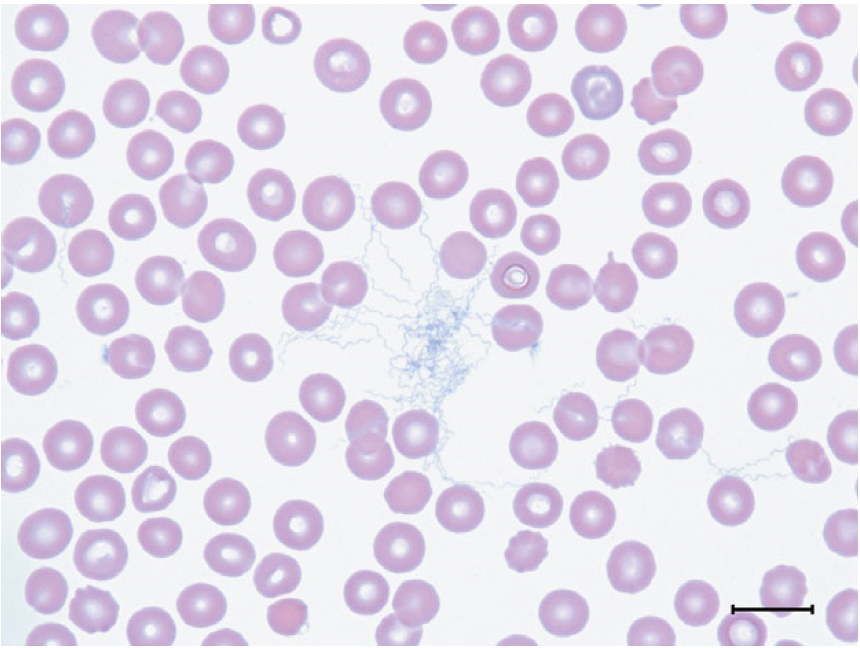
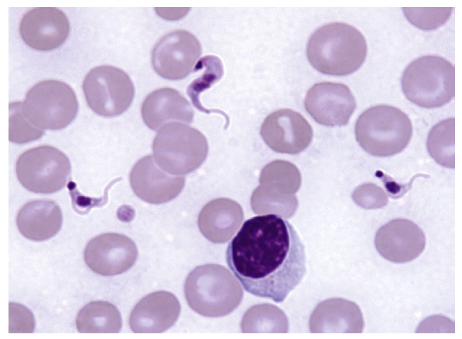

What is the a) causative agent, b) pathogenesis/life cycle, and c) clinicopathological changes encountered in schistosomiasis in dogs?
Graham JVIM 2021
a) Heterobilharzia americana (HA) - trematode parasite. Endemic to the Gulf Coast regions of the USA, also reported in Kansas, North Carolina & Indiana.
b) Exposure when immersed in freshwater lakes or streams harboring lymnaeid snails (intermediate host). Free swimming cercariae emerge from the infected snail, penetrate the dog’s skin, and then migrate hematogenously
to the lungs and liver, where sexual maturation takes place –> adult parasites travel via the portal system to the mesenteric veins to mate –> release fertilized eggs into the mesenteric veins and use proteolytic enzymes to migrate through the intestinal walls –> shed in faeces. Upon contact with fresh water, flagellated miracidia emerge from the eggs and infect the snails –> complete life cycle.
c) CSx - D+ +/- hematochezia, weight loss, hyporexia or anorexia, V+, , lethargy, PUPD. CBC - lymphopenia, eosinophilia, anemia, thrombocytopenia. Biochem - hyperglob (polyclonal gammopathy reported), azotemia, increased liver eyzymes, hyperCa (34-50%).
Ehrlichia canis - name:
- Vector
- Intracellular or extracellular
- Which cells affected
- Bloodwork changes with chronic infection
- Immune cells involved during infection
- Diagnostic methods
- Treatment
- Common co-infections
- Rhipicephalus sanguineus (brown dog tick)
- Intracellular
- Monocytes
- Pancytopenia
- T lymphocytes (impt for protective immunity during infection) - note immunosuppressive drugs that suppress T Lc
- Doxycycline 10mg/kg/d x4 wks - clears EC DNA from blood, BM, spleen, liver & lungs; but likely still persistent infection –> recrudescence possible.
Leptospirosis - which serogroups are covered by bivalent (L2) vs quadrivalent (L4) vaccines?
L2: Canicola, Icterohaemorrhagiae
L4: L2 + Australis, Grippotyphosa
Echinococcosis
1. Major species?
2. Intermediate & definitive hosts?
3. Main clinical manifestations in small animals & transmission routes?
4. Public health risk?
- E granulosis, E multilocularis (tapeworms)
- Dogs - definitive hosts, people - IH
- 2 main forms.
- Autochthonous cystic echinococcosis - common where dogs access infected livestock offal (sheep). Endemic in Alaska, north-central USA, some western states
- Alveolar echinococcosis - common where dogs eat rodents (IH). Northern hemisphere. (Also occurs in people, slowly progressive disease, 100% fatality if untreated). - Yes, zoonotic. People become infected by ingesting eggs after handling infected dog faeces, or petting infected dogs with ova on body, or contact with contaminated food/water/soil.
Organism?
Transmission route?
Treatment?
Which test is useful for diagnosis & monitoring tx response?

Pythiosis insidosum (dogs)
Ingestion of zoospores in water sources (ponds, wetlands etc.)
Surgical removal of infected tissues
Anti-fungal tx x 3-6mths – itraconazole, terbinafine, IV amp B
(medical manaement alone <10% cured)
ELISA-based anti-P insidiosum antibody assay (serum)
Organism?
Risk factors?
Major virulence factor & role?
Clinical presentations - dogs vs cats?

Blastomyces dermatitidis (NB: broad based budding)
Young adult, med to large-breed dogs, dogs involved in outdoor activities, access to water bodies/soil/excavation sites (NB: indoor cats can get it too)
BAD-1 (cell surface glycoprotein) - binds to host cell receptors on macrophages, also helps evasion of host immune response (influences cytokine secretion & impairs complement activation).
Dogs - pulmonary (65-85%) > diffuse lymphadneopathy, cutaneous lesions can be small & variable sized, lameness. GI, neuro uncommon.
Cats - GI & neuro more common. Cutaneous lesions usually large abscesses.
What are the two main pathogenic leptospirosis species?
What antigen is used for serotyping?
L interrogans & L kirschneri. (note species NOT serovar)
O antigen.
What type of pathogen is Brucella canis?
What testing is available?
Treatment?
G- bacteria.
- Serology (rapid slide agglutination (RSAT) - good sensitivity >95% but if positive, need to repeat test with 2-mercaptoethanol (2ME) to increase Sp & also confirm with AGID/TAT
- Agar gel immunodiffusion (AGID)) but can take up to 12 weeks to seroconvert.
- PCR good Sn & Sp but $$$$.
- Blood and/or fluid culture options (but zoonotic risk)
Tx
- No abx is 100% effective. Usually enro, rifampicin + doxy combo.
- Castration (NB can still persist in prostate with urine shedding)
- Ideally euth :(
What is the agent that causes Lyme disease?
How is it transmitted?
Name a diagnostic test.
What types of vaccines exist against it?
Borrelia bugdorferi sensu lato.
Tick-borne (Ixodes sp.)
Serology - C6 antibody assay (also detects Abt o OspF)
Vaccines include bacterin (lysed spirochetes) or subunit (often OspA & OspC proteins)
Lyme disease (Bb) - describe the roles of its outer surface proteins.
How are these Osps useful for diagnostic, treatment & prevention purposes?
OspA - allows spirochete to adhere to tick mid-gut (A for adhere)
OspC - upregulated when tick ingests mammalian blood (OspA is downregulated). OspC binds tick salivary gland protein to evade immune response + binds to mammalian plasminogen & disseminate within host. Acute infection (3 weeks) C for chomp, circumvent & conquer
VlsE lipoprotein - undergoes recombinational shuffling of genetic code to evade host immunity. V for vary
**OspF **- chronic infection. F for forever
Utility:
- SNAP 4dx + quantitative ELISA (C6) - detects Ab against VlsE
- Multiplex fluorescent assay - Ab against OspA, OspC, OspF
- Bb vaccines induce anti-OspA Ab +/- other Osp. So tests to detect C6, VIsE OspC & OspF can differentiate between natural vs. vaccine-induced Ab as these Ab are not in the vaccine.
Name the agent most commonly implicated in:
- SNA Aspergillosis in dogs
- SNA Aspergillosis in cats
- SOA Aspergillosis in cats
- Disseminated Aspergillosis in dogs
- Disseminated Aspergillosis in cats
- SNA: A fumigatus (dogs & cats)
- SOA: A felis (cats)
- Disseminated: A terreus (dogs), A fumigatus (cats)
Pneumonyssoides caninum - what is this organism? What clinical signs can this cause?
Nasal mite.
URT signs - reverse sneezing.
What agent?
Vector?
Most common hematologic abnormality?
Treatment?
Borrelia turicatae & Borrelia hermsii (spirochetes) aka Tick Borne Relapsing Fever.
Vector = Ornithodoros spp. (soft ticks)
Thrombocytopenia
Tetracyclines
Agent?
Mode of transmission?
Other diagnostic methods?
Treatment?

Cytauxzoon felis. Schizont in macrophage (rare in blood film but usually find at feathered edge).
Tick borne disease (vector = Amblyomma americanum (Lone Star) tick). Bobcats are reservoir host.
Dx: positive PCR or seeing piroplasm merozoites in RBCs (NB: can be present in clinically silent carrier infections)
Atovaquone & azithromycin (superior to imidocarb)
Causal agent (including stage)?
Vector?
Treatment options (include those from recent literature)?
Trypanosoma Cruzi, trypomastigotes (looks like seahorse)
Reduviid (kissing bugs) - Triatoma spp.
No labelled drugs. Current recc - benznidazole, nifurtimox
New drugs - amiodarone & itraconazole (synergistic in disrupting parasite ergosterol synthesis & calcium homeostasis)
- What is the life stage of Leishmania in the sandfly vs host?
- What is the vector?
- Treatments for Leishmaniasis & MOA?
- Clinical response
- Promastigote in the sandfly. Amastigote in the host.
- Sandflies
- Meglumine antimoniate & allopurinol (meglumine monotherapy rarely effective to clear infection, drug combo is synergistic + reduced risk of drug resistance)
* Meglumine selectively inhibit the leishmanial enzymes required for glycolytic and fatty acid oxidation.
* Allopurinol inhibits Leishmania spp activity by limiting available purines in the host that are required for protozoal survival. Allopurinol is taken up by the protozoa and metabolized into a toxic compound (4-amino-pyrazole-pyrimidine), which incorporates into the parasite’s RNA, causing death. - Remission in 65-100%, can take months
What is the case definition of a rabies-positive animal?
IFA positive (preferably on CNS tissue) or isolation of rabies in cell culture or a lab animal.
In which of the systemic mycoses is antigen testing NOT recommended?
Coccidiodomycosis - poor Sn 20%. Antibody testing (EIA) is sensitive and specific, so preferred.
Features differentiating atypical bacteria (nocardia, mycobact, actinomyces)?
Nocardia: acid-fast, filamentous, monomicrobial
Actinomyces: non-AF, filamentous, polymicrobial
Mycobact: AF, intracellular (in Mp/Np), bacilli
What % of dogs infected with Brucella suis remain asymptomatic?
40% subclinical
What is a highly sensitive first-line test for diagnosis of Brucella canis in dogs? What additional step in the test assay can be performed to increase specificity? What should you do if you have a positive result for this first-line test?
RSAT (rapid slide agglutination test), Sn >95%. Low false neg (ddx abx up to 4-6wks prior, not yet seroconverted ~4-12wks).
False pos due to X-rxn with other G- bact.
If RSAT positive, either:
- Add 2-ME (2-mercaptoethanol) to inhibit IgM X-rxn & increase test specificity.
- Repeat test with AGID or tube agglutination test (TAT)
- Repeat test at 12wks
What drug is used for monotherapy to treat Leishmaniasis & MOA? What stages of disease may monotherapy be considered?
Allopurinol. MOA - inhibits protozoal activity by interfering with the purine pathway & protozoal RNA synthesis. Drug uptake by Leish is metabolised into a toxic compound (4-amino-pyrazole-pyrimidine) which incorporates into its RNA & causes death. Given long-term (min 6 months, usually 1 year+)
Stage 1 (mild CSx, normal bloodwork, non-azotemic, non-proteinuric) OR
Stage 4 (stage 3-4 CKD with nephrotic syndrome, UPC >5, PTE) - as antimony drugs are nephrotoxic
Pneumocystis canis:
- Where does its life cycle occur?
- Predisposed breeds
- Treatments?
Alveolar epithelial cells (trophozoites > cysts)
Young CKCS, Mini Dach
TMPS, folic acid, supportive care. NOT anti-fungals (resistant).
What are the main species & vector(s) causing Bartonellosis in dogs vs cats?
What are the virulence factors of Bartonella?
D/C: B. henselae - C felis (fleas)
D: B. vinsonii & rochalimae - Rhipicephalus sanguineus
C: also B. clarridgeae - fleas
Virulence factors - type IV secretory systems (T4SS) (transports protozoal effector proteins to target cells) + adhesions (allows binding to endothelial cells). Inhibit host cell apoptosis which allows continuous replication > reach critical #s in circulation without causing hemolysis but enough to be picked up by arthropod during bite.



